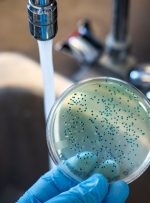
حصبه؛ علائم، عوارض، روش تشخیص، درمان و پیشگیری

[ad_1] حصبه یا تب تیفوئید عفونتی باکتریایی است و میتواند بسیار خطرناک یا حتی کشنده باشد. این عفونت معمولا از طریق غذا و آب آلوده منتقل میشود، به همین دلیل بهراحتی قابلپیشگیری است. حصبه بیشتر در مناطقی شیوع دارد که افراد کمتر دستشان را میشویند. برای آشنایی با علائم این بیماری، روشهای پیشگیری از آن












